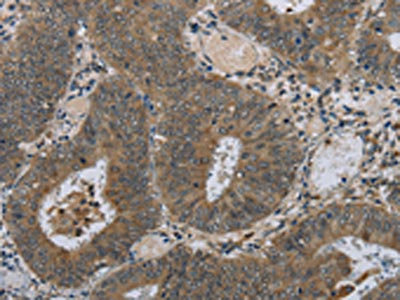

-
中文名稱:HSD3B1兔多克隆抗體
-
貨號:CSB-PA976299
-
規格:¥1100
-
圖片:
-
其他:
產品詳情
-
Uniprot No.:
-
基因名:HSD3B1
-
別名:HSD3B1; 3BH; HSDB3A; 3 beta-hydroxysteroid dehydrogenase/Delta 5-->4-isomerase type 1; 3 beta-hydroxysteroid dehydrogenase/Delta 5-->4-isomerase type I; 3-beta-HSD I; 3-beta-hydroxy-5-ene steroid dehydrogenase; 3-beta-hydroxy-Delta(5-steroid dehydrogenase; 3-beta-hydroxysteroid 3-dehydrogenase; Delta-5-3-ketosteroid isomerase; Dihydrotestosterone oxidoreductase; Steroid Delta-isomerase; Trophoblast antigen FDO161G
-
宿主:Rabbit
-
反應種屬:Human
-
免疫原:Fusion protein of Human HSD3B1
-
免疫原種屬:Homo sapiens (Human)
-
標記方式:Non-conjugated
-
抗體亞型:IgG
-
純化方式:Antigen affinity purification
-
濃度:It differs from different batches. Please contact us to confirm it.
-
保存緩沖液:-20°C, pH7.4 PBS, 0.05% NaN3, 40% Glycerol
-
產品提供形式:Liquid
-
應用范圍:ELISA,IHC
-
推薦稀釋比:
Application Recommended Dilution ELISA 1:2000-1:5000 IHC 1:50-1:200 -
Protocols:
-
儲存條件:Upon receipt, store at -20°C or -80°C. Avoid repeated freeze.
-
貨期:Basically, we can dispatch the products out in 1-3 working days after receiving your orders. Delivery time maybe differs from different purchasing way or location, please kindly consult your local distributors for specific delivery time.
-
用途:For Research Use Only. Not for use in diagnostic or therapeutic procedures.
相關產品
靶點詳情
-
功能:A bifunctional enzyme responsible for the oxidation and isomerization of 3beta-hydroxy-Delta(5)-steroid precursors to 3-oxo-Delta(4)-steroids, an essential step in steroid hormone biosynthesis. Specifically catalyzes the conversion of pregnenolone to progesterone, 17alpha-hydroxypregnenolone to 17alpha-hydroxyprogesterone, dehydroepiandrosterone (DHEA) to 4-androstenedione, and androstenediol to testosterone. Additionally, catalyzes the interconversion between 3beta-hydroxy and 3-oxo-5alpha-androstane steroids controlling the bioavalability of the active forms. Specifically converts dihydrotestosterone to its inactive form 5alpha-androstanediol, that does not bind androgen receptor/AR. Also converts androstanedione, a precursor of testosterone and estrone, to epiandrosterone. Expected to use NAD(+) as preferred electron donor for the 3beta-hydroxy-steroid dehydrogenase activity and NADPH for the 3-ketosteroid reductase activity.
-
基因功能參考文獻:
- High HSD3B1 Expression is Associated with Cancer Progression in Breast Cancer. PMID: 28744792
- Fungicide ziram may disrupt the placental steroid production. In the present study, we investigated the effects of ziram on steroid formation in human placental cell line JEG-3 cells and on HSD3B1 and aromatase in the human placenta. Ziram did not inhibit progesterone production in JEG-3 cells and HSD3B1 activity at 100muM... ziram is a potent inhibitor of human aromatase. PMID: 28951168
- This is the first study to indicate that 3beta-HSD type 1 is a potent prognostic factor in hormone-dependent breast cancer. PMID: 27139182
- HSD3B1 is involved in aldosterone production, despite its lower levels of expression compared with HSD3B2, and also possibly associated with KCNJ5 mutation in aldosterone-producing adenoma. PMID: 25458695
- Expression of the genes HSD3B1, HSD17B3, and SRD5A2 was significantly increased in BPH tissues compared to normal adjacent prostate tissues. PMID: 24810473
- prostate cancer patients who harbored the heterozygous variant HSD3B1 (1245C) are more likely to develop to castration-resistant prostate cancer but do not have shorter time to biochemical recurrence, shorter survival time or higher mortality risk PMID: 25731771
- No evidence to support that HSD3B1 is involved in aldosterone synthesis in the human adrenal cortex or that genetic variation in HSD3B1 affects blood pressure or hypertension. PMID: 24951726
- Results indicate that orexin-A significantly enhanced the expression of 3beta-hydroxysteroid dehydrogenase (3beta-HSD) and the production of cortisol, and increased the phosphorylation of AKT protein in the NCI-H295R adrenocortical cells. PMID: 25319929
- The data of this study supports a strongly positive association between mitochondrial complex I gene variations and MS pathogenesis in a Filipino population. PMID: 25172194
- The AAT haplotype of the HSD3B1 gene was significantly associated with increased risks of acne vulgaris in Han Chinese from the Southwest China. PMID: 24157973
- HSD3B1 T-->C Leu338, HTR2A T102C, GNAS T393C, and RGS2 G638A polymorphisms were not associated with hypertension risk. PMID: 23859711
- Risk-conferring genetic variations in the HSD3beta gene influenced susceptibility of primary aldosteronism. Concomitant presence of rs6203 CC and rs12410453 GA genotypes synergistically increased aldosterone-to-renin ratio PMID: 24006038
- Study shows that castration-resistant prostate cancer sometimes expresses a gain-of-stability mutation that leads to a gain-of-function in 3betaHSD1, which catalyzes the initial rate-limiting step in conversion of the adrenal-derived steroid dehydroepiandrosterone to dihydrotestosterone. PMID: 23993097
- elevated in placental tissue of women with polycystic ovarian syndrome PMID: 23122578
- HSD3B1 is a highly specific trophoblast-associated marker that can be used in the distinction of trophoblastic tumorlike lesions and tumors from nontrophoblastic lesions and tumors. PMID: 23318910
- The aim of this haplotype-based case-control study was to estimate whether polymorphisms of the maternal estrogen synthesis genes (CYP19A1, HSD3B1 and HSD3B2) are associated with preeclampsia and gestational hypertension PMID: 22638611
- Carriers of HSD3B1 GCC haplotype had lower peak early (Ea; P = 0.004) and higher peak late (Aa; P = 0.066) diastolic mitral annular velocities and therefore a lower Ea/Aa ratio (P = 0.041) as compared with noncarriers PMID: 22673022
- The HSD3B1 T/C polymorphism cannot be used as genetic marker for the risk for recurrent spontaneous abortions in our Caucasian population. PMID: 21631238
- There is expression of 3beta-Hsd1 in XX gonads during gonad differentiation period. PMID: 21932034
- rs6203 and rs1047303 in the HSD3B1 gene are useful genetic markers for essential hypertension, while polymorphisms of HSD3B1 are associated with the BP and aldosterone level. PMID: 20660004
- The study identifies an amino acid in the steroid binding domain of human 3-beta-HSD I that may be exploited to produce new inhibitors that are much more highly specific for 3-beta-HSD I in breast tumors compared to adrenal 3-beta-HSD II. PMID: 20420909
- We investigated associations between single nucleotide polymorphisms in genes HSD3B1, SRD5A1/2, and AKR1C2 and prostate cancer risk PMID: 20056642
- Data indicate that enzymes CYP17A1 and HSD3B1 showed low expression, while AKR1C3 and SRD5A1 were abundantly expressed. PMID: 20086173
- nonstop mutation in the stop codon and missense mutation in type II 3beta-hydroxysteroid dehydrogenase gene causing 3beta-HSD deficiency congenital adrenal hyperplasia. PMID: 12050213
- Polymorphism in exon 4 of the human gene and blood presssure PMID: 12054649
- Structure/function relationships responsible for the kinetic differences between isoforms PMID: 12205101
- HSD3B1 was identified using a trifunctional phenyl sulfonate probe. PMID: 12438565
- Substantially higher affinity of 3beta-HSD1 activity for substrate and inhibitor steroids relative to the 3beta-HSD2 enzyme. PMID: 12530651
- In outer region of adrenal cortex immunoreactivity was observed for 3beta-hydroxysteroid dehydrogenase. PMID: 12530676
- Structure/function relationships responsible for coenzyme specificity and the isomerase activity of this multienzyme complex. PMID: 12832414
- Descending HSD3B phenotype in hyperandrogenic females is associated with a variant of insulin-resistant polycystic ovary syndrome. PMID: 14764797
- Neither of the HSD3B1 or PTP1B variants were associated with hypertension PMID: 15097232
- results designate YY1 as the factor responsible for the intron 1-mediated boost of the HSD3B2 gene basal promoter activity PMID: 15291746
- further characterizes structure/function relationships of human 3beta-HSD and bring us closer to the goal of selectively inhibiting the type 1 enzyme in placenta to control the timing of labor or in hormone-sensitive breast tumors to slow their growth PMID: 15291757
- identification of structural reasons for the substantially higher affinities of 3beta-HSD1 for substrates, coenzymes, and inhibitors PMID: 15797861
- The Rossmann-fold domain of 3beta-HSD1 contains two Cys residues, Cys72 and Cys111, which are capable of forming an intrasubunit disulfide bond based on their proximity in our structural model. PMID: 17624763
- Variant in the HSD3B1 gene is associated with increased mammographic density PMID: 17627014
- There is a possible role in human disease of common genetic variation in HSD3B1 and HSD3B2. PMID: 17689071
- results suggest that the HSD3B1 N367T and UGT2B17 null polymorphisms may modify the risk of prostate cancer, particularly among men with a family history of the disease PMID: 17826523
- HSD3B1 is highly specific and sensitive compared with other trophoblastic markers dor differential diagnosis of trophoblastic tumors and tumorlike lesions.. PMID: 18223326
- Structure/function of the inhibition of HSD3B1 by trilostane is reported. PMID: 18524572
- The activity levels of 17beta-hydroxysteroid dehydrogenase (17beta-HSD), 3beta-hydroxysteroid dehydrogenase (3beta-HSD), 3alpha-hydroxysteroid dehydrogenase (3alpha-HSD/3-KSR) and estrone sulfatase in ovarian epithelial carcinomas, were assayed. PMID: 18723074
- Anti-inflammatory effects of IL-1alpha and IL-4 on 3beta-HSD2 mRNA involve a p38 MAPK signalling pathway, whereas pro-inflammatory response of IL-1alpha to 3beta-HSD1 mRNA involves a NF-kappaB inflammatory pathway. PMID: 18778748
- The high affinity, competitive inhibition of 3beta-HSD1 by trilostane and epostane may be related to the presence of Arg195 in 3beta-HSD1 vs. Pro195 in 3beta-HSD2. PMID: 18955108
- The genetic polymorphisms of the HSD3B1,genes were found to be significantly different (p<0.05) between the uremic and non-uremic diabetes group PMID: 19148546
- Among patients with essential hypertension, cholesterol side-chain cleavage & MDR1 loci are related to circulating endogenous ouabain & DBP. In contrast, variants in HSD3B1 are related with SBP probably via aldosterone PMID: 19197249
- 3beta-HSD protein was immunodetectable in primary ascites of women who were diagnosed with epithelial ovarian cancer but mRNA transcripts of both 3beta-hydroxysteroid dehydrogenase type 1 and type 2 were diminished relative to normal cells. PMID: 19414525
- compared (+)- and (-)-gossypols in the inhibition of 3beta-HSD and 17beta-HSD3 in human and rat testes PMID: 19429456
顯示更多
收起更多
-
亞細胞定位:Endoplasmic reticulum membrane; Single-pass membrane protein. Mitochondrion membrane; Single-pass membrane protein.
-
蛋白家族:3-beta-HSD family
-
組織特異性:Placenta and skin. Predominantly expressed in mammary gland tissue.
-
數據庫鏈接:
Most popular with customers
-
-
YWHAB Recombinant Monoclonal Antibody
Applications: ELISA, WB, IHC, IF, FC
Species Reactivity: Human, Mouse, Rat
-
Phospho-YAP1 (S127) Recombinant Monoclonal Antibody
Applications: ELISA, WB, IHC
Species Reactivity: Human
-
-
-
-
-